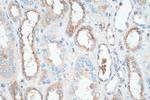
Cystatin C Antibody in Immunohistochemistry (Paraffin) (IHC (P))

Search
Proteintech
Cystatin C Recombinant Rabbit Monoclonal Antibody (1I20)
{{$productOrderCtrl.translations['antibody.pdp.commerceCard.promotion.promotions']}}
{{$productOrderCtrl.translations['antibody.pdp.commerceCard.promotion.viewpromo']}}
{{$productOrderCtrl.translations['antibody.pdp.commerceCard.promotion.promocode']}}: {{promo.promoCode}} {{promo.promoTitle}} {{promo.promoDescription}}. {{$productOrderCtrl.translations['antibody.pdp.commerceCard.promotion.learnmore']}}
产品信息
82441-1-RR
种属反应
宿主/亚型
Expression System
分类
类型
克隆号
抗原
偶联物
形式
纯化类型
保存液
内含物
保存条件
运输条件
产品详细信息
Immunogen sequence: AGSSPGKPPR LVGGPMDASV EEEGVRRALD FAVGEYNKAS NDMYHSRALQ VVRARKQIVA GVNYFLDVEL GRTTCTKTQP NLDNCPFHDQ PHLKRKAFCS FQIYAVPWQG TMTLSKSTCQ DA
靶标信息
Cystatin C, a member of the type 2 cystatin superfamily, is a potent inhibitor of cysteine proteinases, both endogenous (lysosomal cathepsins), and pathogenic. Cystatin C is a 13 kDa secreted protein which is found in high concentrations in biological fluids and is thought to be expressed by all human nucleated cells. Changes in Cystatin C have been documented in a number of cardiovascular diseases, including atherosclerosis, amyloid angiopathy and myocardial infarction. Its low molecular weight also means that Cystatin C can be used as a marker of renal failure.
仅用于科研。不用于诊断过程。未经明确授权不得转售。
篇参考文献 (0)
生物信息学
蛋白别名: AD8; bA218C14.4 (cystatin C); CST3; cystatin 3; Cystatin-3; Cystatin-C; Cystatin3; CystatinC; epididymis secretory protein Li 2; Gamma-trace; MGC117328; Neuroendocrine basic polypeptide; OTTHUMP00000030440; OTTHUMP00000164181; OTTHUMP00000164182; OTTMUSP00000016736; Post-gamma-globulin; RP23-250M11.9; unnamed protein product
基因别名: ADLDWA; ARMD11; CST3; HEL-S-2
UniProt ID: (Human) P01034
Entrez Gene ID: (Human) 1471